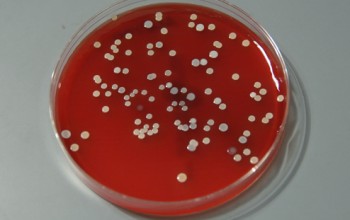

В почве встречаются все формы микроорганизмов которые есть на Земле: бактерии, вирусы, актиномицеты, дрожжи, грибы, простейшие, растения. Общее микробное число в 1 г почвы может достигать 1–5 млрд. Наибольшее количество микроорганизмов встречается в самых верхних слоях (1-2-5 см), а в отдельных почвах они распространены до глубины 30-40 см.
Контролю с применением санитарно-микробиологических исследований (бактериологический, гельминтологический или паразитарный, энтомологический анализы) подлежат почвы и грунты территорий детских и лечебно-профилактических учреждений, сельских поселений, не канализованных районов городских населенных пунктов, территории первого пояса зоны санитарной охраны источников хозяйственно-питьевого водоснабжения, зоны свалок, отвальных площадок, а так же сельскохозяйственные поля, орошаемые водой из открытых водоемов, городскими промышленными стоками, стоками животноводческих ферм, удобряемые навозом, территории строительства.
Санитарно-бактериологический анализ для оценки санитарного состояния почв включает определение обязательных показателей:
- Индекс бактерий группы кишечной палочки (индекс БГКП);
- Индекс энтерококков (фекальные стрептококки);
- Патогенные бактерии (патогенные энтеробактерии, в т.ч. сальмонеллы, энтеровирусы).
Эти бактерии служат показателями фекальной загрязнённости почвы. Наличие в почве бактерий Streptococcus faecalis (стрептококков фекальных) или Escherihia coli (грамотрицательная кишечная палочка) говорит о свежем фекальном загрязнении. Присутствие таких микроорганизмов, как Clostridium perfringens (возбудитель токсикоинфекций), определяет давнее загрязнение.
Из всех объектов окружающей среды почва наиболее часто и интенсивно загрязняется возбудителями кишечных паразитарных заболеваний (гельминтозы, лямблиоз, амебиаз и др). Почва для яиц геогельминтов (аскарид, власоглавов, токсокар, анкилостомид, стронгилоидес и др.) является неотъемлемой средой прохождения их биологического цикла развития и местом временного пребывания для яиц биогельминтов (описторхи, дифиллоботрииды, тенииды и др.), а также цист кишечных патогенных простейших (криптоспоридий, изоспор, лямблий, балантидий, дизентерийной амебы и др.).
При оценке эпидемической опасности и степени загрязнения почвы возбудителями паразитарных болезней определяют:
Санитарно-энтомологическими показателями являются личинки и куколки синантропных мух. Синантропные мухи (комнатные, домовые, мясные и др.) имеют важное эпидемиологическое значение как механические переносчики возбудителей ряда инфекционных и инвазионных болезней человека (цисты кишечных патогенных простейших, яйца гельминтов и др.).
Критерием оценки санитарно-энтомологического состояния почвы является отсутствие или наличие преимагинальных (личинки и куколки) форм синантропных мух на площадке размером 20х20 см. Наличие личинок и куколок в почве населенных мест является показателем неудовлетворительного санитарного состояния почвы и указывает на плохую очистку территории, неправильное хранение бытовых отходов и их несвоевременное удаление.
В санитарно-эпидемиологическом отношении почвы и грунты населенных мест могут быть разделены на следующие категории по уровню биологического загрязнения: чистая, умеренно опасная, опасная, чрезвычайно опасная. Вы можете заказать анализ почвы и грунтов в нашей лаборатории.
Оценка уровня биологического загрязнения почв и грунтов
| Категория загрязнения почв и грунтов | Индекс БГКП | Индекс энтеро-кокков | Патогенные |
бактерии, в т.ч. сальмонеллы
Яйца гельминтов, экз/кг Личинки-Л
куколки-К мух, экз. в почве с площадью 20 х 20 см
Чистая 1-10 1-10 — Умеренно опасная 10-100 10-100 — 1-10 Л до 10 К — отс. Опасная 100-1000 100-1000 — 10-100 Л до 100 К до 10 Чрезвычайно опасная 1000 и выше 1000 и выше — 100 и выше Л>100 К>10
Природная вода из различных источников всегда содержит некоторое количество химических соединений, разнообразную микрофлору, яйца гельминтов, вирусы, которые могут быть причиной интоксикации, а также заболеваний эпидемиологического и эндемического характера. Вода – один из путей передачи возбудителей заболеваний, в частности инфекционных. Инфекции, предающиеся преимущественно через воду, называются водными. К ним относятся: брюшной тиф, дизентерия, сальмонеллезы, холера, инфекционный гепатит, полиомиелит, туляремия, лептоспирозы. Передаются через воду заболевания кожных покровов и слизистых оболочек (трахома, чесотка, грибковые заболевания, аденовирусные конъюнктивиты). Вода может играть важную роль и в передаче возбудителей ряда зоонозных инфекций, главным образом среди животных (сап, ящур, сибирская язва, сальмонеллез). Загрязнение воды патогенными микробами происходит многими путями. Наиболее распространенный из них – спуск в водоемы неочищенных сточных вод, в частности инфекционных больниц, ветеринарных лечебниц, промышленных предприятий, перерабатывающих животное сырье, банно-прачечных предприятий. Фекальное загрязнение водоемов, в частности колодцев, может вызываться кроме этого поверхностными водами в периоды ливневых дождей и таяния снегов, а также почвенными водами, если в них проникают нечистоты из выгребных ям. При центральном водоснабжении становится возможным загрязнение воды не только в месте водозабора, но и в головных сооружениях, а также в водоразводящей сети, чаще всего в случаях нарушения герметичности водопроводных труб и других аварий или подсоединения технических водопроводов к водопроводам питьевым. Водоемы могут загрязняться и выделениями диких животных, главным образом грызунов, которые с мочой и фекалиями могут выделять в воду возбудителей таких, например болезней как туляремия и лептоспирозы. Вода, загрязненная патогенными микробами, может вызвать массовые заболевания (эпидемии). Вода искусственных бассейнов при недостаточной очистке и обеззараживании может также быть передатчиком ряда инфекционных заболеваний. В загрязненной воде часто присутствуют стафилококки, стрептококки, возбудители дизентерии, полиомиелита и др.
Показатели бактериологического загрязнения воды:
Микробное число воды – общее количество микробов, содержащихся в 1 мл воды; Титр кишечной палочки – наименьший объем воды, в котором обнаруживается одна кишечная палочка; Индекс кишечной палочки – количество кишечных палочек в 1 л воды.
Микробное число воды показывает, насколько благоприятны или неблагоприятны условия для жизни микробов. В норме в 1 мл водопроводной воды не должно быть более 100, а в колодезной –более 1000 микробов.
Кишечная палочка, обычно обитающая в толстом кишечнике человека и животных, служит показателем свежего загрязнения воды экскрементами животных и человека. В соответствии с гигиеническими нормами титр кишечной палочки для водопроводной питьевой воды установлен не менее 300 мл. Индекс кишечной палочки – 3 (наличие в 100 мл воды не более 3 кишечных палочек). Для колодезной воды титр кишечной палочки не должен быть более 100.
Гигиеническим показателем качества воды является также наличие в ней яиц гельминтов. В питьевой воде и воде крытых бассейнов яйца гельминтов должны отсутствовать.
Флора и фауна воды. Не допускает содержания в питьевой воде видимых на глаз водных организмов.
Источники водоснабжения. Основные источники водоснабжения – закрытые водоемы (подземные воды) и открытые озера, пруды, водохранилища).
Показатели качества источника централизованного хозяйственно-питьевого водоснабжения.
| Определяемые показатели | 1-й класс | 2-й класс | 3-й класс |
| Подземные источники | |||
| Мутность, мг/дм³не более | 1,5 | 1,5 | 10 |
| Цветность, град, не более | 20 | 20 | 50 |
| Водородный показатель (рН) | 6-9 | 6-9 | 6-9 |
| Железо,мг/дм³не более | 0,3 | 10 | 20 |
| Марганец, мг/дм³ | 0,1 | 1 | |
| Сероводород.мг/дм³ | отсутствие | 3 | 10 |
| Фтор,мг/дм³ | 1,5-0,7 | 1,5-0,7 | 5 |
| Число бактерий группы кишечной палочки в 1 дм³ | 3 | 100 | 1000 |
| Поверхностные источники водоснабжения | |||
| Мутность | 20 | 1500 | 10000 |
| Цветность | 35 | 120 | 200 |
| Запах при 20° и 60° более, баллы | 2 | 3 | 4 |
| Водородный показатель | 6,5-8,5 | 6,5-8,5 | 6,5-8,5 |
| Железо | 1 | 3 | 5 |
| Марганец | 0,1 | 1 | 2 |
| БПК полное, мг по килороду/дм³с | 3 | 5 | 7 |
| Число лактозоположительных кишечных палочек в дм³воды | 1000 | 10000 | 50000 |
Очистка и обеззараживание воды:
Первый этап – очистка воды от взвешенных частиц отстаиванием в специальных отстойниках ( горизонтальных и вертикальных) и фильтрацией. Для ускорения используется коагуляция – очистка воды с помощью специальных химических соединений – коагулянтов (сернокислый алюминий – глинозем), он вступает в реакцию с солями кальция и магния, образует с ними гидраты в виде хлопьев, оседающих на дно очистных сооружений.
Второй этап- фильтрация. После коагуляции вода фильтруется. Фильтры: прямоугольные резервуары площадью 50-100 м², с речным песком высотой 0,6-1м, под которым слой гравия и дренажные трубы для отвода профильтрованной воды. После 8-12 часов фильтр промывается обратным током воды.
Третий этап – дезинфекция. В нашей стране – это хлорирование газообразным хлором. Это один из самых старых, дешевых простых и достаточно надежных способов обеззараживания воды. Применяется также озонирование, и обработка УФЛ. Озонирование улучшает вкус воды и органолептические свойства воды, но это дорого, требует сложной и дорогой аппаратуры, тщательного контроля
В толстой кишке у здорового человека микроорганизмы, составляющие основу микрофлоры, представлены анаэробами: бифидобактериями и лактобактериями, а также аэробами – кишечной палочкой (E. coli) с нормальными ферментативными свойствами. Эти микроорганизмы обеспечивают стабильность нормальной микрофлоры и предотвращают заселение толстого кишечника посторонними микроорганизмами.
Условно-патогенные микроорганизмы, обитающие в кишечнике, представители семейства энтеробактерий: клебсиеллы, энтеробактер, протей, цитробактер, синегнойная палочка, стафилококки и др., составляют значительную часть нормальной аэробной (нуждающейся для развития в притоке кислорода) флоры кишечника и обычно не вызывают заболеваний, а наоборот, участвуют в обеспечении его нормального функционирования. Но когда их количество превышает норму, это может вызвать кишечные расстройства.
| Микрофлора | Норма у детей | |
|---|---|---|
| Младше года | Старше года | |
| Патогенные энтеробактерии | ||
| Общее количество кишечной палочки | 300 – 400 млн/г | 400 -1млрд/г |
| Кишечная палочка с нормальной ферментативной активностью (эшерихии) (Escherichia coli). | 10 7 –10 8 | 10 7 –10 8 |
| Кишечная палочка со слабо выраженными ферментативными свойствами | 10 –10 11 | 10 9 –10 10 |
| Лактобактерии | 10 6 –10 7 | 10 7 –10 8 |
| Бактероиды | 10 7 –10 8 | 10 9 –10 10 |
| Энтерококки | 10 5 –10 7 | 10 5 –10 8 |
| Эубактерии | 10 6 –10 7 | 10 9 –10 10 |
| Пептострептококки | 5 | 10 9 –10 10 |
| Клостридии | 3 | 5 |
| Стафилококк золотистый (S. aureus) | ||
| Стафилококки (сапрофитный эпидермальный) | 4 | 4 |
| Дрожжеподобные грибы рода Candida | 3 | 4 |
| Другие условно-патогенные энтеробактерии | ||
| Клебсиелла (Klebsiella) | 4 | 4 |
| Энтеробактер (Enterobacter) | 4 | 4 |
| Графния (Hafnia) | 4 | 4 |
| Серрация (Serratia) | 4 | 4 |
| Протей (Proteus) | 4 | 4 |
| Morganella | 4 | 4 |
| Providecia | 4 | 4 |
| Цитробактер (Citrobacter) | 4 | 4 |
| Неферментирующие бактерии | ||
| Псевдомонады (Pseudomonas) | 3 | 4 |
| Ацинетобактер (Acinetobacter) | 3 | 4 |
Патогенные энтеробактерии – являются причиной большого числа различных заболеваний человека. К ним относятся бактерии, которые вызывают острую кишечную инфекцию (ОКИ): сальмонеллы, шигеллы – возбудители дизентерии. Выявление этих микроорганизмов является показателем серьезного инфекционного заболевания кишечника. Кишечная палочка (эшерихия коли, сокращенное e. coli) – входит в состав нормальной микрофлоры желудочно-кишечного тракта человека.
Снижение общего количества кишечной палочки может быть признаком присутствия в кишечнике таких паразитов как глисты.
Кишечная палочка со сниженной ферментативной активностью – это неполноценная кишечная палочка, от которой нет ни вреда, ни пользы. Однако присутствие показателя больше нормы является признаком начинающегося дисбактериоза.
В фекалиях здорового ребенка кишечные палочки (типичные) выявляются в количестве 10 7 —10 8 кое/г, при этом количество лактозонегативных кишечных палочек не должно превышать 10 5 кое/г, а гемолитические (гемолизирующие) кишечные палочки должны отсутствовать.
Гемолитические (гемолизирующие) кишечные палочки способны вырабатывать токсины, действующие на нервную систему и на кишечник, могут вызвать аллергические и кишечные проблемы, в норме должны отсутствовать
Лактозонегативные энтеробактерии – группа условно-патогенных бактерий, мешающая нормальному пищеварению и вызывающие диспептические явления у ребенка, то есть изжогу, отрыжку, чувство давления или распирания в животе. Их количество не должно превышать 5% (или в титрах: 10 4 – 10 5 – умеренное повышение).
Лактобактерии – один из важнейших в группе молочнокислых бактерий, расщепляют лактозу (молочный сахар) и препятствуют развитию лактазной недостаточности, поддерживают кислотность толстой кишки на уровне 5,5–5,6 рН. Лактобактерии активируют фагоцитоз (процесс, при котором специальные клетки крови и тканей организма (фагоциты) захватывают и переваривают возбудителей инфекционных заболеваний и отмершие клетки). Лактобактерии входят в состав материнского молока.
Бифидобактерии — важнейший представитель микрофлоры организма человека; в толстой кишке детей составляют около 95 % популяции бактерий. Бифидобактерии угнетают рост болезнетворных бактерий, тормозит их рост и размножение, поэтому дефицит бифидобактерий является одним из патогенетических факторов длительных кишечных нарушений у детей. Различные штаммы бифидобактерий и бактероиды появляются в желудочно-кишечном тракте спустя 10 дней после рождения. Дети, рожденные путём кесарева сечения, имеют значительно более низкое содержание бактерий, чем появившиеся естественным путем. Существенное снижение количества бифидобактерий – признак выраженного дисбактериоза.
Энтерококки входят в состав нормальной микрофлоры желудочно-кишечного тракта человека, однако они являются также и возбудителями инфекций мочевыводящих путей, инфекций органов малого таза. При избыточном росте энтерококков рекомендовано применение бактериофагов. Энтерококки присутствуют в кишечнике в количествах 10 5 – 10 8 кое/г фекалий и в норме не должны превышать общее количество кишечных палочек.
Клостридии входят в состав нормофлоры желудочно-кишечного тракта.
Протей – представитель нормальной, условно-патогенной микрофлоры кишечника. Протеи считаются санитарно-показательными бактериями. Количество обнаруживаемых протей рассматривают как показатель загрязнения. Пути передачи – внутрибольничное заражение, а также – заражение при несоблюдении правил личной гигиены.
Клебсиелла — условно-патогенная бактерия семейства энтеробактерий, входящая в состав нормальной микрофлоры желудочно-кишечного тракта, но может вызывать ряд гастроэнтерологических заболеваний. Клебсиеллез является одной из распространенных внутрибольничных инфекций. При больших титрах лечение проводят бактериофагами.
Цитробактер, энтеробактер, протеи, клебсиеллы и другие при снижении иммунитета организма могут приводить к изменению функции кишечника, формированию воспалительных процессов в различных органах.
Бактероиды – это условно-патогенные бактерии, представители нормальной микрофлоры человека. Заселение кишечника бактероидами происходит постепенно. Они обычно не регистрируются в бактерийных картах фекалий у детей первого полугодия жизни; у детей в возрасте от 7 месяцев до 1 – 2 лет содержание бактероидов не превышает 10 8 кое/г. Роль бактероидов до конца не выяснена, но установлено, что они принимают участие в пищеварении, расщепляют желчные кислоты, участвуют в процессах липидного обмена.
Стафилококки – негемолитические (эпидермальные, сапрофитирующие) – входят в группу сапрофитной микрофлоры, попадающей в организм из объектов окружающей среды. Количество их не должно превышать 10 4 кое/г фекалий.
Золотистый стафилококк грудничку может попасть через грудное молоко. Даже небольшие его количества может вызвать выраженные клинические проявления (сильнейший понос, рвоту, боли в животе), особенно у детей первых месяцев жизни. Поэтому в нормах, приведенных в бланке анализа, указывается, что его быть не должно. Патогенность золотистого стафилококка напрямую зависит от состояния нормальной флоры: чем больше бифидобактерий, лактобактерий и нормальной кишечной палочки, тем меньше вреда от стафилококка.
В клинической картине дисбактериоза кишечника, обусловленного стафилококком, отмечаются симптомы, связанные с интоксикацией и воспалительным процессом, развивающимся в кишечнике: повышение температуры (до 39 °C) с ознобом и потливостью, головная боль, слабость, плохой аппетит, нарушение сна, постоянная или схваткообразная боль в животе, жидкий обильный стул с кровью и слизью. Частота стула – до 7 – 10 раз в сутки. Регистрируется вздутие живота, длительная болезненность по ходу толстого кишечника, спазм. Изменения крови характеризуются увеличением количества лейкоцитов, сдвигом лейкоцитарной формулы влево и повышением СОЭ, снижением альбуминовой и повышением глобулиновой фракций, а при тяжелом течении – снижением содержания общего белка (до 6,1 г/л).
Дрожжеподобные грибы рода Candida – повышение титров может быть после применения антибиотиков. Если количество грибов повышено, а количество нормальной кишечной флоры резко снижено, при этом отмечается кандидоз (молочница) видимых слизистых оболочек (ротовая полость, половые органы) – это проявления системного кандидоза, то есть имеется инфицирование грибами кишечника.
При обнаружении в посевах дрожжеподобных грибов рода Candida до 10 7 кое/г фекалий ситуация оценивается как дисбактериоз кишечника. Если в посевах определяется более 10 7 кое/г фекалий и клиническая картина свидетельствует о генерализации процесса (поражение кожи, слизистых оболочек и внутренних органов), такие случаи рассматриваются как кандидомикоз или кандидомикозный сепсис.
При кандидомикозе у детей боль локализируется в области пупка, в животе чувство вздутия и тяжести. Стул жидкий или кашицеобразный со слизью, иногда с кровью или пенистый, с наличием беловато-серых или серовато-зеленых микотических комочков или пленок до 6 раз и более в сутки.
Что такое E. coli
Микроскоп позволяет увидеть, как они выглядят. E. coli лактозонегативные и другие эшерихии действительно похожи на короткие палочки с округлыми концами. Шириной они до 0,8 мкм, длиной до 3 мкм. Иногда эти бактерии концами соединяются друг с другом, образуя цепочки. Снаружи их оболочка покрыта пилями – ворсинками, помогающими микробу закрепляться на стенках кишечника и быть нечувствительными ко многим антибиотикам. На конце у эшерихий есть жгутик, с помощью которого они довольно быстро перемещаются. Поэтому, попав, например, в половые органы, они способны переместиться в почки, простату, мочевой пузырь.
Лактозонегативные E. coli являются факультативными анаэробами, то есть для их жизнедеятельности кислород не нужен, но его присутствие они переносят без труда.
Эти бактерии, как и все эшерихии, имеют множество штаммов, различающихся между собой некоторыми внешними признаками, реакцией на антибиотики, выделяемыми токсинами и другими особенностями.
Польза кишечных палочек
В некоторых источниках указывается, что E. coli лактозонегативные попадают в ЖКТ плода еще в материнской утробе, но большинство бактериологов склонны считать, что они заселяют кишечник младенца в первые двое суток после появления на свет. В желудке E. coli не задерживаются, потому что там для них неподходящая среда. Проникнув в кишечник, они прикрепляются к его стенкам, где и живут все время, пока жив их носитель. Пока их там 10*5 КОЕ/г (это всего 1 % от всех микроорганизмов в кишечнике), они занимаются полезным делом:
- вырабатывают витамины группы В, лактат, янтарную, муравьиную, уксусную и молочную кислоты, биотин, витамин К;
- перерабатывают кислород, чем способствуют жизнедеятельности бифидобактерий, без которых не может быть нормального переваривания пищи;
- не дают многим патогенным бактериям поселиться в толстой кишке.
Другими словами, в определенных количествах эти бактерии необходимы. Отдельные штаммы даже используют как пробиотик и целенаправленно вводят в кишечник при некоторых заболеваниях. Поэтому если анализ показал их наличие в норме, значит, нет никакой патологии.
E. coli лактозонегативные: пролиферация. Что это такое?
Если слишком размножившимся бактериям через изъязвления в стенках кишечника удалось проникнуть в кровь, они разносятся по многим органам, вызывая различные заболевания, такие как менингит, гастроэнтерит, перитонит, сепсис.
Дисбактериоз у грудничка: причины и симптомы
В нормальном состоянии у младенцев в кишечнике обязательно должны присутствовать полезные бактерии. Если лактозонегативные E. coli повышены, у грудничка может начаться дисбактериоз. Это происходит по причине низкого иммунитета у новорожденных деток и неспособности их организма контролировать численность бактерий. Признаки заболевания:
- вздутие животика;
- метеоризм;
- частые срыгивания, иногда рвота;
- урчание в животе;
- диарея (кал водянистый, пенистый, с характерным запахом);
- аллергический дерматит;
- потеря в весе.
В кале могут наблюдаться непереваренные крупинки пищи, слизь.
Если малыш испражняется слишком часто, возможно обезвоживание. Его симптомы:
- редкое мочеиспускание;
- слабость;
- сухость губ, языка.
Кроме нарушения числа условно патогенных E. coli, в первые дни и недели после рождения дисбактериоз может начаться из-за попадания в систему ЖКТ младенца энтеропатогенных кишечных палочек. Заразиться ими можно с молоком матери, через грязную соску, игрушки, мединструменты, плохо вымытые руки матери или медперсонала, недостаточно обработанную бутылочку. У грудничков на искусственном вскармливании заражение патогенными эшерихиями бывает, если молочные смеси приготовлены с нарушением технологии. При этом к общим симптомам дисбактериоза (понос, рвота, вздутие животика) добавляются температура и кровянистые прожилки в кале.
Диагностика и лечение дисбактериоза у младенцев
При подозрении на расстройство работы кишечника у детей берут анализы кала на дисбактериоз и копрограмму. Собирать материал для анализа лучше с пеленки, а не с подгузника.
Если состояние ребенка до года тяжелое, его обязательно госпитализируют. В больнице проводится комплексная терапия, направленная на недопущение обезвоживания (маленьким детям ставят капельницы с регидратационными растворами) и на снижение показателей кишечной палочки.
Если наблюдается избыточная пролиферация кишечной палочки, и у ребенка развился менингит или другие тяжелые осложнения, лечение проводят антибиотиками.
В случаях обнаружения в кале младенца патогенных кишечных палочек, лечение обязательно. Оно проводится антибиотиками, регидратационными растворами, пробиотиками и пребиотиками.
Дисбактериоз у детей старше года
Считается, что у малышей возрастом старше 1 года нарушение работы кишечника возникает по тем же причинам, что и у взрослых. E. coli лактозонегативные повышены у ребенка бывают в таких случаях:
- очень слабый иммунитет;
- продолжительный прием антибиотиков, особенно если лечение этими препаратами проводится по инициативе родителей, а не по назначению доктора.
Симптомы дисбактериоза у детей старше года такие же, как и у грудничков:
- боли в животе;
- жидкий стул более 2 раз в день;
- урчание в области кишечника;
- метеоризм;
- рвота;
- общее недомогание.
В редких случаях дисбактериоз сопровождается запорами либо чередованием запоров и поносов.
Такая же нестабильность дефекации наблюдается, если E. coli лактозонегативные понижены. Если анализ выявил количество этих бактерий ниже нормы, это может указывать на наличие глистов.
Кроме того, у детей старше года возможно инфицирование опасными кишечными палочками: энтеротоксигенной (прикрепляется к стенкам кишечника и выделяет токсины, провоцирующие понос), энтероинвазивной (вызывает симптомы, сходные с шингеллезом и дизентерией), энтерогеморрагической (могут наблюдаться поносы с кровяными прожилками, боли в животе имеют резкий схваткообразный характер).
К заражению этими видами E. coli приводит:
- употребление в пищу немытых или обсемененных продуктов, особенно кисломолочных;
- любой телесный контакт с больным ребенком или взрослым (например, совместная игра, из-за чего вспышки дисбактериоза часто регистрируются в детских садах и яслях);
- использование обсемененных кишечными палочками предметов (игрушек, посуды).
Диагностика и лечение дисбактериоза у детей
При наличии у ребенка поноса и других симптомов нарушения работы органов ЖКТ, необходимо сдать анализы:
- копрограмму;
- кал на дисбактериоз.
Иногда выполняют бакпосев мочи и рвотных масс на наличие в материале кишечных палочек.
Энтерогеморрагические палочки в результатах анализов должны отсутствовать. E. coli лактозонегативные в кале у детей старше года и взрослых должны оставаться в пределах 10*5 КОЕ/г. При этом в целом всех условно-патогенных E. coli должно быть от 10*7 до 10*8 КОЕ/г. Если этот показатель уменьшен до значений 10*6 КОЕ/г, диагностируют дисбактериоз I степени, а если увеличен до 10*9 КОЕ/г и выше – дисбактериоз II степени.
Если дисбактериоз сопровождается температурой от 38 °C, назначают жаропонижающие препараты.
Кишечные палочки у женщин
Если у женщин E. coli лактозонегативные повышены в кале, диагностируется дисбактериоз II степени. Вызвать его могут:
- тяжелые заболевания любой этиологии, приведшие к снижению иммунитета;
- бесконтрольный или длительный прием антибиотиков.
Попадание в кишечник других патогенных E. coli возможно в таких ситуациях:
- употребление некачественной воды и пищи;
- телесный контакт (например, рукопожатие) с носителем бактерии;
- несоблюдение гигиены;
- пользование предметами обихода, на которых имеются кишечные палочки (надо заметить, что они во внешней среде очень живучи, подолгу могут существовать в почве, в продуктах питания и в воде).
В большинстве случаев заболевание проходит без приема антибиотиков. Методы лечения:
- жесткая диета;
- обильное питье;
- прием энтеросорбентов.
Гораздо опаснее, если обнаружены лактозонегативные E. coli в моче или во влагалище, потому что в норме их там быть не должно. Попадают бактерии в несвойственную им среду при неправильной гигиене или ее отсутствии (без регулярного подмывания кишечные палочки, вышедшие из толстой кишки с каловыми массами, остаются на теле и проникают во влагалище), при ношении тесного белья, особенно стрингов, при незащищенном половом акте с носителем бактерии.
Если во влагалище обнаружена E. coli лактозонегативная, как лечить такое заболевание? И обязательно ли это делать, если женщина не чувствует дискомфорта? Кишечные палочки, попав в половые органы, могут переместиться оттуда в уретру, мочевой пузырь, яичники, матку. Струей мочи они не вымываются и практически всегда вызывают воспаление, которое без должного лечения переходит в хроническую форму. То есть женщина становится носительницей E. coli. При этом явные симптомы могут отсутствовать, наблюдаются только выделения из влагалища с характерным неприятным запахом и некоторый дискомфорт во время полового акта. Переохлаждение, стресс, плохое питание, любое заболевание могут спровоцировать переход хронической формы в острую, поэтому если анализ показал наличие во влагалище лактозонегативных E. coli, лечение проводится обязательно. В курс терапии входит прием антибиотиков и общеукрепляющих средств. Через месяц нужно повторить анализ. Если палочка в мазке или в моче вновь обнаружена, назначают второй курс, но с другими антибиотиками.
Кишечные палочки у беременных
Как уже отмечалось выше, E. coli лактозонегативная (кишечная палочка) присутствует в ЖКТ у всех людей, не принося никаких проблем. У женщин в период беременности иммунитет ослабляется, что часто приводит к выходу численности эшерихий за пределы нормы. При этом сама женщина может не ощущать дискомфорта, а изменение микрофлоры ее кишечника обнаруживается только по результатам анализов.
Гораздо хуже, когда у беременной наблюдаются такие симптомы дисбактериоза:
Частые акты дефекации и рвота приводят к обезвоживанию, что негативно сказывается на развитии малыша в утробе матери. Кроме того, при наличии слишком большого числа бактерий происходит интоксикация организма беременной продуктами их жизнедеятельности. Также диарея чревата повышением тонуса матки, что грозит преждевременными родами. Запоры неблагоприятны для всех людей (а особенно для беременных) тем, что ненужные вещества, находящиеся в каловых массах, не выводятся из организма, а поступают обратно в кровь.
Лечение лактозонегативной E. coli у беременных проводится по общей схеме:
- строгая диета;
- прием регидрантов;
- питье чаев, киселей, отваров из сухофруктов;
- прием энтеросорбентов.
Кишечные палочки у мужчин
Лактозонегативные E coli повышены у взрослого мужчины в кале? Если показатели отличаются от нормы – это свидетельствует о дисбактериозе. Причины его возникновения, симптомы и методы лечения – такие же, как для женщин. Попадание кишечных бактерий в уретру полового органа мужчины вызывает уретрит, который может протекать в острой форме (с сильными болевыми ощущениями при мочеиспускании) всего один-два дня, а далее без лечения перейти в хроническую.

